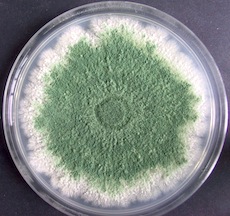

-
-
-
Tổng tiền thanh toán:
-
CÁC LOẠI NẤM VI SINH ỨNG DỤNG TRONG NÔNG NGHIỆP - PHẦN 1
Viết bởi Fameko, Ngày 17/06/2021
1: Trichoderma spp – giải pháp diệt tuyến trùng, nấm bệnh và thúc đẩy sự phát triển cho cây trồng
Thách thức gần đây đối với ngành nông nghiệp tiên tiến phải đối mặt là làm sao để diệt được tuyến trùng và nấm bệnh cho cây trồng, đồng thời đạt được năng suất cao hơn theo cách thuận tự nhiên, thân thiện môi trường, không gây độc hại cho môi trường cũng như người làm nông.
Vì vậy, các nhà khoa học đã nghiên cứu để tìm ra các giải pháp thân thiện môi trường, đó là ứng dụng rộng rãi hơn các chất diệt khuẩn sinh học.
Trong số các loại nấm và vi khuẩn sinh học được sử dụng làm chất diệt khuẩn thì nấm Trichoderma tạo ra các enzyme khác nhau đóng vai trò chính trong hoạt động kiểm soát sinh học, chống lại tuyến trùng, nấm bệnh trên các loại cây trồng khác nhau.
Trichoderma spp có mặt khắp nơi trong môi trường
Các chủng Trichoderma ssp chủ yếu là nấm sinh sản vô tính có mặt trong tất cả các loại đất nông nghiệp và cả trong gỗ mục nát. Hoạt động đối kháng của Trichoderma ssp cho thấy nó ký sinh trên nhiều mầm bệnh từ đất và tán lá.
Trichoderma ssp là loại nấm có tính xâm lấn mạnh mẽ, phát triển nhanh, sản xuất bào tử khi môi trường bất lợi để tồn tại lâu dài và được coi là “nhà sản xuất kháng sinh” mạnh mẽ ngay cả trong môi trường cạnh tranh cao về không gian, chất dinh dưỡng và ánh sáng. Những nghiên cứu gần đây cho thấy loại nấm này không chỉ đóng vai trò là chất diệt khuẩn mà còn kích thích sức đề kháng của cây và sự tăng trưởng, phát triển của cây dẫn đến tăng sản lượng cây trồng.
Hiện nay, Trichoderma spp đang được sử dụng để kiểm soát các bệnh thực vật theo hệ thống quản lý bệnh bền vững.
Trichoderma ssp– chất diệt khuẩn sinh học trong nông nghiệp hiện đại
Theo kết quả nghiên cứu cho thấy Trichoderma spp có khả năng đối kháng với một loạt các mầm bệnh truyền qua đất có hại cho cây trồng: bệnh vàng lá thối rễ, chết nhanh chết chậm, lá xoăn, cây bị rụng hoa rụng quả hàng loạt…
Thông thường để xử lý vấn đề này, bà con nông dân có thói quen sử dụng các loại thuốc hóa học, chất kích thích để điều trị.
Tuy nhiên, thực tế là sau một thời gian cách làm này không còn hiệu quả. Bởi tuyến trùng và các loại nấm bệnh này có cơ chế tự thích ứng với môi trường mới nên vẫn sống khỏe, khiến cho cây trồng bị trơ thuốc, còi cọc chậm phát triển.
Ngoài ra, việc sử dụng các loại thuốc hóa học còn làm cho đất đai bị chai cứng, không hấp thụ được chất dinh dưỡng, gây ảnh hưởng lớn đến sức khỏe cũng như kinh tế của người làm nông.
Chính bởi vậy, với nền nông nghiệp hiện đại ngày nay, việc tìm kiếm và sử dụng các sản phẩm phân bón hữu cơ sinh học, giúp diệt trừ tuyến trùng và nấm bệnh cho cây trồng, giúp đất tơi xốp, bảo vệ sức khỏe cho người làm nông, phát triển nền nông nghiệp một cách bền vững đã trở thành lựa chọn hàng đầu với nhiều bà con nông dân.
Cơ chế hoạt động của Trichoderma ssp:
Cơ chế hoạt động chủ yếu của nấm Trichoderma ssp là ký sinh nấm, kháng sinh, cạnh tranh chất dinh dưỡng và không gian; sự chịu đựng các điều kiện bất lợi bằng việc gia tăng sự phát triển của cây và rễ; làm hòa tan và cô lập chất dinh dưỡng vô cơ, cảm ứng sự kháng bệnh, bất hoạt enzyme gây bệnh.
Cạnh tranh chất dinh dưỡng và không gian sống: Trichoderma ssp là loại vi khuẩn đối kháng có khả năng gây ức chế hoặc làm chậm sự tăng trưởng và các hoạt động khác của nấm gây bệnh, do đó tạo ra lợi thế sinh thái so với các đối thủ cạnh tranh. Các vi khuẩn đối kháng sử dụng nguồn lực sẵn có để tăng trưởng, khiến mầm bệnh không đủ chất dinh dưỡng để phát triển và bị bỏ đói. Trichoderma có khả năng huy động và sử dụng các chất dinh dưỡng của đất, làm cho nó có hiệu quả và có tính cạnh tranh hơn nhiều loại vi khuẩn đất khác.
Ký sinh nấm: Trichoderma ssp có khả năng ký sinh, ức chế hoặc thậm chí tiêu diệt các loại nấm gây bệnh thực vật khác, do đó nó được cho là một biện pháp kiểm soát sinh học. Việc ký sinh nấm là cơ chế trực tiếp để kiểm soát sinh học bằng cách ký sinh, phát hiện, phát triển và xâm chiếm mầm bệnh. Chính vì khả năng ký sinh này mà Trichoderma ssp được sử dụng rộng rãi để kiểm soát đối với nấm gây bệnh và tuyến trùng kí sinh.
Thúc đẩy sự phát triển của cây trồng: các vi sinh vật xâm chiếm hệ thống rễ của cây, bảo vệ cây khỏi mầm bệnh từ đất cũng như kích thích sự phát triển của cây. Trichoderma spp sinh sôi nảy nở trong Rhizosphere (vi khuẩn sống trong đất xung quanh rễ), do đó cải thiện dinh dưỡng và tăng trưởng cây trồng một cách tự nhiên. Nó có thể xâm chiếm rễ cây, cải thiện dinh dưỡng, tăng trưởng và phát triển cây trồng cũng như tăng cường sức đề kháng của thực vật đối với các ức chế phi sinh học.
Kháng sinh: Trichoderma spp là nguồn phong phú và quan trọng của các chất chuyển hóa thứ cấp được sử dụng để kiểm soát sinh học các bệnh thực vật. Kháng sinh xảy ra trong các tương tác giữa một cây chủ, mầm bệnh và Trichoderma spp dẫn đến việc sản xuất kháng sinh và các hợp chất trọng lượng phân tử thấp của Trichoderma để ức chế sự phát triển của nấm gây bệnh.
2: Nấm xanh Metarhizium – giải pháp diệt trừ côn trùng, sâu bọ cho cây trồng
Các loài côn trùng gây hại như: rầy nâu, bọ xít, châu chấu, cào cào, mối, sâu ăn lá, ve gia súc… đã gây thiệt hại lớn về kinh tế và nông nghiệp ở nhiều nơi trên thế giới. Các trung gian truyền bệnh sốt rét, sốt xuất huyết và bệnh giun chỉ là Aedes spp, Anopheles spp, và Culex spp đã gây ra dịch bệnh và gây tử vong hàng năm.
Để loại bỏ các loài gây hại và trung gian truyền bệnh này, thông thường bà con nông dân hay sử dụng các loại thuốc trừ sâu hóa học như một giải pháp.
Tuy nhiên, việc áp dụng thuốc trừ sâu hóa học đã gây ra ô nhiễm nước ngầm và ảnh hưởng có hại tới sức khỏe con người, gia súc, gia cầm và thiên địch. Bên cạnh đó, sự phát triển tính kháng của các loại sâu bệnh, mối mọt và trung gian truyền bệnh này đã thúc đẩy các nhà khoa học nghiên cứu chuyên sâu việc thay thế thuốc trừ sâu hóa học bằng các tác nhân kiểm soát sinh học như vi khuẩn, virus và nấm.
Vai trò của Nấm Xanh
Nấm xanh Metarhizium được nghiên cứu rộng rãi bởi phạm vi tác động vật chủ hẹp, an toàn, thân thiện với môi trường và dễ dàng để sản xuất hàng loạt. Loại nấm này thuộc nhóm Hyphomycetes, sinh sản bởi các bào tử phân bào gọi là conidia.
Khi các bào tử phân bào của nấm xanh tiếp xúc với cơ thể vật chủ là các côn trùng, chúng sẽ nảy mầm và sợi nấm xuất hiện xuyên qua lớp biểu bì.
Sau đó nấm phát triển bên trong cơ thể, cuối cùng giết chết côn trùng sau vài ngày; hiệu ứng gây chết côn trùng này rất có thể được hỗ trợ bởi việc sản xuất các peptide tuần hoàn thuốc trừ sâu (chất phá hủy).
Biểu bì của xác chết thường trở thành màu đỏ. Nếu độ ẩm môi trường đủ cao, mốc trắng sau đó phát triển trên xác chết sẽ sớm chuyển sang màu xanh khi bào tử được sản sinh.
Nấm xanh Metarhizium là loài nấm ký sinh trên các loài sâu cánh vảy, rầy nâu, bọ xít, bọ trĩ, bọ cánh cứng… có thể gây bệnh và làm chết với khoảng 50 họ gồm khoảng 200 côn trùng.
Cơ chế gây nhiễm trùng của Metarhizium đối với vật chủ của chúng

Các bào tử conidial bám dính vào lớp biểu bì của vật chủ và bắt đầu nảy nầm. Sự phát triển của các bào tử trên bề mặt lớp biểu bì xảy ra ở một mức độ hạn chế, trong đó nấm lấy được dinh dưỡng từ chất béo trong lớp biểu bì.
Metarhizium hình thành nên appressorium (tạo ra đầu mút của ống nấm phình to, là nơi tạo ra một áp suất lớn nhằm tạo điều kiện cho vòi xâm nhiễm xâm nhập vào trong biểu bì của vật chủ) đánh dấu sự bắt đầu xâm nhập vào côn trùng. Các appressorium tạo ra một chốt thâm nhập vào bộ xương ngoài (lớp biểu bì) của vật chủ.
Sau khi thâm nhập vào bên trong cơ thể vật chủ. Sợi nấm tiếp tục phát triển cho đến khi chúng lấp đầy toàn bộ cơ thể côn trùng. Giai đoạn thâm nhập này liên quan đến việc tiết ra các protein như Subtilisin, trypsin, chymotrypsin và carboxypeptidase, tiêu hóa các tế bào dưới da giàu protein của côn trùng.
Trong quá trình sinh bào tử, sợi nấm thoát ra khỏi lớp biểu bì của côn trùng ra môi trường bên ngoài. Metarhizium tạo thành một mạng lưới dày đặc hơn và tạo ra các bào tử màu xanh lá cây trên xác chết của vật chủ bị nhiễm bệnh.
3: Nấm trắng - giải pháp đa dạng diệt trừ côn trùng, sâu bọ cho cây trồng
Nấm trắng thuộc họ Moniliales, lớp Deuteromycetes, sinh sống ký sinh trên cơ thể sâu non bộ cánh vảy, nấm này thường được dùng làm thuốc trừ sâu sinh học. Nấm trắng còn có tên khoa học là Beauveria bassiana… Loài này được biết đến và phân lập lần đầu trên cơ thể sâu non sâu đục thân ngô Ostrinia nubilalis (bộ cánh vảy, họ Pyralidae) ở miền Bắc nước Pháp. Nhiều nòi thuộc nấm này được dùng làm thuốc trừ sâu.
Đối tượng mà nấm trắng hướng đến là các loài côn trùng thuộc bộ cánh vảy, cánh cứng, cánh màng, cánh thẳng, cánh đều, cánh nửa và luôn cả nhện. Tại Việt Nam, nấm trắng rất hiệu quả trong việc tiêu diệt những loài côn trùng như rầy nâu, rầy lưng trắng, bọ xít, sâu cuốn lá lúa, sâu đo đay, sâu róm thông, nhện vàng, nhện đỏ, nhện trắng,…
Cơ chế chung của việc lây nhiễm này bao gồm các giai đoạn sau:

Chúng tiêu diệt sâu bằng cách lây lan conidi của nấm, nhờ giá thể mà chúng bấu víu vào cơ thể côn trùng, tiến hành thâm nhập qua lớp biểu bì, vào khoang cơ thể côn trùng, tạo ra nhiều tiểu thể trong huyết tương. Những tiểu thể này ăn mòn các tế bào bạch huyết, làm chết côn trùng. Cơ thể côn trùng chứa đầy mầm bệnh, hình tướng cơ thể không bị biến dạng nhưng có trở nên rắn hơn. Khi gặp độ ẩm thích hợp, nấm trổ ra khỏi bề mặt cơ thể sâu hại, tạo ra lớp sợi nấm màu trắng trên cơ thể sâu. Lớp sợi nấm này lại tạo conidi để tiếp tục truyền nhiễm sang các sâu non khác.